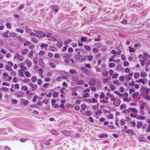

Erythema Annulare Centrifugum =الحمامى الحلقية النابذة
Erythema Annulare
Centrifugum and
Other Figurate
Erythemas
The figurate erythemas include a variety of eruptions characterized by annular and polycyclic lesions. Classification of this group has always been controversial; the literature abounds with contradictions, uncertainties and a bewildering array of synonyms. Darier in 1916 was the first to use the term erythema annulare centrifugum (EAC), although similar lesions had been described previously under other names. Table 42-1 lists the figurate erythemas and the differential diagnoses to consider.
▪ EPIDEMIOLOGY
EAC is an uncommon disorder. No epidemiologic data are available. There are only two large series in the literature: 66 cases identified clinically and 73 first diagnosed histologically. EAC appears to have no predilection for either sex or for any age group. Erythema gyratum perstans is an older synonym for familial EAC.
▪ ETIOLOGY AND PATHOGENESIS
Almost certainly EAC is not a single disease but a clinical finding with many causes. Both the annularity and the peripheral spread of EAC have attracted speculation as to a possible mechanism. Most hypotheses have centered around interactions among inflammatory cells, their mediators, and ground substance as foreign antigens diffuse through the skin.
ERYTHEMA ANNULARE
CENTRIFUGUM AT A GLANCE
|
|
- Clinical pattern of annular expanding erythematous rings, which enlarge rapidly, fade, and then disappear, as new lesions appear.
- Diagnosis of erythema annulare centrifugum is one of exclusion.
- Superficial and deep variants can be separated clinically and histologically. Deep form is often lupus tumidus.
- No single cause.
|
Migrating Erythemas |
||||||||||||||||||||||||||||||||||||||||||||||||
|
The cause of most cases of EAC is unknown. In one series, 24 patients were closely evaluated, and in none of the cases was any definite cause found. Bacterial or candidal infections are most often suspected as triggers. Autoimmune diseases are also occasionally associated.9 The hormonal changes of menses or pregnancy have been implicated as well. Although medications are often identified as causing EAC in case reports, none regularly induces such lesions. EAC may be coupled with malignant neoplasms, with the eruption disappearing after treatment of the tumor and often returning as the tumor recurs. This paraneoplastic marker must be distinguished from metastatic tumors with an annular pattern.
▪ CLINICAL FINDINGS
History
The history is most important in exploring the differential diagnostic considerations. In general the lesions are asymptomatic but may be cosmetically disturbing.
Cutaneous Lesions
EAC presents as one or more lesions that begin as erythematous macules or urticarial papules and enlarge by peripheral extension to form ringed, arcuate, or polycyclic figures . They spread gradually to form large rings with central clearing, with the edges of the lesions often advancing several millimeters a day . After a variable period of time, the lesions disappear, often to be replaced by new ones. In some cases annual recurrence has been described.
Two sub-types of EAC can be identified both clinically and histologically16:
- Superficial gyrate erythema has an indistinct border and trailing scale and may be pruritic
- Deep gyrate erythema has a firm yet indurated border, lacks scale, and is less often pruritic .
Additional findings may point to an underlying disorder, but most patients have no systemic signs or symptoms.
▪ LABORATORY TESTS
Histopathology
Superficial EAC has epidermal changes of parakeratosis and spongiosis, with a superficial perivascular infiltrate . Deep EAC lacks epidermal damage and has intense lymphohistiocytic cuffing about both the superficial and deep vessels . There is minimal papillary dermal edema and no spongiosis. One should search carefully for mucin as a clue to lupus erythematosus.
Other Laboratory Tests
There are no other laboratory tests diagnostic for EAC.
▪ DIFFERENTIAL DIAGNOSIS
The differential diagnostic challenge in EAC is twofold. First one must exclude other eruptions that can appear similar, such as erythema migrans as the first sign of borreliosis or erythema gyratum repens, which is generally more rapidly moving and usually reflects an underlying malignancy . In addition, there are diseases that can clinically present as EAC, but biopsy will provide a different answer. Included in this group are leukocytoclastic vasculitis, granulomatous disorders, metastases, and eosinophilic infiltrates.
Then comes the problem of the many odd disorders that cause confusion, because they seem to have distinctive features but are rarely encountered . Prime examples are annular erythemas associated with the carrier state of chronic granulomatous disease or a lactate dehydrogenase M-subunit deficiency. There are also neutrophilic and lichenoid variants of EAC. Familial EAC, originally described as erythema gyratum perstans, is rare. Finally, there is the broad spectrum of annular erythemas of infancy, including neonatal lupus erythematosus, Malassezia furfur infections, and the idiopathic variants which themselves may show eosinophilic or neutrophilic infiltrates, as well as atrophy.
Box 42-1 Differential Diagnosis of Erythema Annulare Centrifugum (EAC)
Most Likely
- Dermatophyte infections
- Tinea versicolor
- Erythema migrans
- Annular urticaria
- Lupus erythematosus
- Lupus tumidus for deep EAC
- Subacute lupus erythematosus for superficial EAC
- Annular psoriasis
Consider
- Erythema multiforme
- Granulomatous diseases (granuloma annulare, actinic granuloma, sarcoidosis)
- Bullous pemphigoid (urticarial phase)
- Leukocytoclastic vasculitis (especially in children)
- Erythema marginatum
- Erythema gyratum repens
- Necrolytic migratory erythema
- Hypereosinophilic syndrome
- Carrier state chronic granulomatous disease
- Hereditary lactase dehydrogenase M-subunit deficiency
- Familial annular erythema
- Annular erythemas of infancy
Always Rule Out
- Lupus erythematosus
- Underlying tumor or annular metastasis
▪ PROGNOSIS AND CLINICAL
COURSE
EAC tends to be a chronic disease, which waxes and wanes. The course is determined by associated diseases or triggers.
▪ TREATMENT
Although an assiduous search for the underlying cause is the primary goal of treatment, only symptomatic relief is available. Systemic glucocorticoids usually suppress EAC, but recurrence is common when these drugs are stopped. Systemic therapy with antipruritics may help. Topical vitamin D analogues, perhaps combined with ultraviolet irradiation, are another option. Empiric use of antibiotic, antifungal, or anti-candidal agents has sometimes been useful.27 Biologics may represent yet another option. In general, most of the therapeutic approaches used for chronic urticaria can also be tried for EAC.